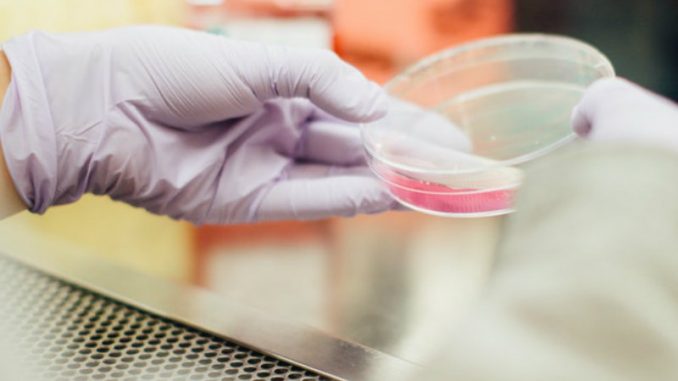

Potrivit Comisiei, statele membre ale Uniunii Europene vor retrage autorizațiile pentru produsele care conțin substanța activă Desmedipham în cel mult 6 luni de la data intrării în vigoare a prezentului regulament. Orice perioadă de grație acordată statelor membre va expira în cel mult 12 luni.
Desmedipham este un erbicid utilizat în tratamentele de post-emergență ale culturilor de sfeclă de zahăr și furajă pentru controlul şi combaterea buruienilor cu frunză lată.
Prezentul regulament nu elimină formularea unor noi cereri de aprobare a Desmedifamului în conformitate cu articolul 7 din Regulamentul (CE) nr. 1107/2009.
